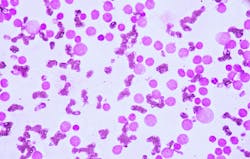
695d2c2c42810da700c36f2c Dreamstime Xxl 86265164 695d2c2c42810da700c36f2c Dreamstime Xxl 86265164

Treating acute myeloid leukemia (AML) depends on knowing what goes wrong inside cells. A new Sylvester Comprehensive Cancer Center at the University of Miami Miller School of Medicine study suggests that two genetic mutations – IDH2 and SRSF2 – work cooperatively to mis-splice RNA messages and change how blood cells develop. The findings appear in the Jan. 2 issue of Science Advances and provide a mechanistic map that could inform future therapies.
The study shows this synergy leads to mis-splicing of key transcriptional regulators—the master switches that determine cell identity.
IDH2 and SRSF2 affect two key systems: the chemical signals that control gene expression and the way RNA is spliced. Understanding both could help improve treatments.
“These mutations don’t act alone—they reshape the cell’s blueprint,” said senior author, Maria Figueroa, M.D., associate director for Translational Research and professor of biochemistry and molecular biology at Sylvester. “When structure and chemical signals work together in the wrong way, the cell’s identity changes. Understanding that process gives us a roadmap for better, more precise treatments.”
The team studied patient samples and lab models using advanced tools to read RNA and map chemical changes in DNA. Here’s what they found:
- When both mutations are present, cells make more splicing errors than when only one mutation is present.
- These mistakes often occur near sites where DNA’s chemical tags have changed, suggesting a link between splicing errors and epigenetic changes.
- The genes most affected are long and complex, which makes them easier to disrupt.
Researchers used artificial intelligence to predict splicing mistakes based on DNA’s chemical patterns.
The study hints that targeting epigenetic modifiers and splicing regulators together might offer new treatment strategies. In lab tests, cells carrying both mutations showed heightened sensitivity to romidepsin, a drug that inhibits chromatin-modifying enzymes—suggesting a potential therapeutic angle.